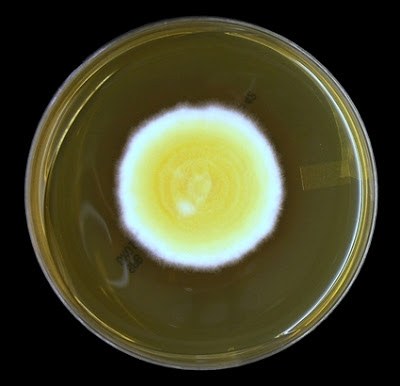
- Colonies ofBlastomyces dermatitidisin SDA after 7 days of growth  (Image source:http://thunderhouse4-yuri.blogspot.com/)

Blastomyces dermatitidis is a thermally dimorphic fungus that grows as a mycelial form in the environment and as a thick-walled budding yeast in tissues (at 37°C). It causes blastomycosis, a chronic granulomatous and suppurative disease also called Gilchrist disease or North American blastomycosis.
B. dermatitidis grows as a mold in warm, moist wooded terrain rich in decaying wood, leaves or debris. Geographically, it is endemic to North America, including the Ohio and Mississippi River valleys and Canada. Blastomycosis cases have also been documented in India, Africa, and Central and South America.

Human infection results following the inhalation of airborne conidia when soil containing microfoci of mycelia is disturbed. Men are affected more often than women, with the ratio of men to women ranging from 4 : 1 to 15 : 1. Although blastomycosis affects immunocompromised individuals, it can affect healthy individuals as well. Infections often develop in people who have contact with soil, work outside, or frequently engage in outdoor activities such as campers, outdoorsmen and hunters. Some cases of human-human transmission have been noted.
Pathogenesis
Alveolar macrophages, neutrophils, and monocyte provide natural resistance to infection with conidia of B. dermatitidis. Alveolar macrophage also inhibits the transformation of conidia to pathogenic yeast form. Yeast form of Blastomyces dermatitidisis very resistant to phagocytosis and killing as it possesses a thick capsule. The proliferation of yeast forms in the alveoli signals the failure of natural resistance to B. dermatitidis.
If natural defenses in the alveoli fail to contain the infection, lymphohematogenous dissemination ensues. This may lead to the involvement of the skin, bone, genitourinary tract, and central nervous system. With the development of immunity pyogranulomatous lesionsappear in lungs and other infected sites followed by the formation of noncaseating granulomas.
Unlike cell-mediated immunity which prevents the progress of blastomycosis, humoral immune responses do not play a significant role in host defense againstB. dermatitidis.
Clinical signs and symptoms
B. dermatitidis is inhaled into the lungs and causes pneumonitis. Clinically, pulmonary symptoms (cough, sputum production, chest pain, and dyspnea) predominate. If not treated or if the immunity failed to contain the pathogen, lymphohematogenous spread may lead to involvement of the skin, bone, and genitourinary tract. The signs and symptoms of which varies according to the site of involvement.
- Pulmonary blastomycosis
- Extrapulmonary blastomycosis
Cutaneous (development of verrucous or ulcerative type of skin lesions) Osseous (osteomyelitis along with contagious tissue abscesses and draining sinuses) Genitourinary (Involvement of prostate and epididymis in men) Central nervous system (Brain abscess, cranial or epidural abscess, and meningitis)
The clinical disease takes two forms, cutaneous and systemic. B. dermatitidis is inhaled into the lungs and causes pneumonitis. Clinically, pulmonary symptoms (cough, sputum production, chest pain, and dyspnea) predominate.
Laboratory diagnosis
Laboratory diagnosis of blastomycosis is based on culture and direct visualization of round, multinucleated yeast forms that produce daughter cells from asingle broad-based bud.
**Sample:**Sputum, bronchoalveolar lavage, biopsy, CSF, bone marrow or pus from the abscess based on the clinical manifestations.
Microscopy and staining:KOH wet mount and hematoxylin & eosin staining are used routinely to check the presence of characteristics yeast cells in the clinical specimens. Presence of characteristics double-contoured, thick-walled, multinucleated yeast forms with single broad-based budding daughter cells confirms the diagnosis but a negative result does not exclude the possibility of blastomycosis.

Sometimes, special staining like Periodic Acid Schiff (PAS) and Gomori Methenamine Silver Stain (GMS) may be required for the identification.
Culture
Currently, culture is the most sensitive method for the diagnosis of blastomycosis. Specimens are inoculated into general-purpose growth media, such as Sabouraud dextrose agar, potato dextrose agar, potato flake agar, or inhibitory mold agar and are incubated at 25 to 30°C for 4 to 6 weeks.
If the specimen is likely to be contaminated with saprophytic fungi and/or bacteria, selective media containing cycloheximide and antibacterial should be used. For tissue specimen use of enrichment culture medium such as brain heart infusion agar supplemented with blood increases the yield.
Growth of the B. dermatitidis will be apparent on fungal isolation media within 10-30 days. Initially, colonies are white to off-white and glabrous or waxy in appearance, which becomes gray to brown as aerial hyphae develop with age.

Microscopic feature (of mold form):
- Delicate septate hyphae measuring 1 to 2 μm in diameter
- Oval or pyriform single-celled conidia measuring 2 to 4 μm in diameter,
- Conidia are found singly at the tips of short or long conidiophores and resemble lollipops

Once sufficient growth of fungi is noted chemiluminescent DNA probe can be used to confirm the isolate as *B. dermatitidis.*Other ways to confirm an identification of B. dermatitidis are checking conversion of the mold to the yeast form (which is very time consuming), repetitive-sequence-based PCR and nucleic acid sequencing.
Antigen Detection
Tests for the detection of B. dermatitidisantigen in urine is available in some reference laboratories. It showed more than 90% sensitivity but specificity is too low. People suffering from histoplasmosis, paracoccidioidomycosis and penicilliosis also give positive results.
Antibody detection tests
Tests for the detection of antibodies to B. dermatitidis are available commercially but not adequate for the diagnosis of blastomycosis.
- Complement fixation test using yeast-phase antigen: Sensitivity and specificity are too low.
- Immunodiffusion using purified B. dermatitidis A antigen: Better than complement fixation test. Sensitivity is around 65-80%.
- Enzyme immunoassays: More sensitive than immunodiffusion but less specific
Nucleic Acid Amplification
Nucleic acid amplification tests for direct detection of B. dermatitidis in clinical specimens are not in routine use.
Treatment
Amphotericin is the treatment of choice. Initial treatment usually requires an amphotericin preparation administered intravenously, followed by oral itraconazole.
Special acknowledgement
I am grateful to yuri for the beautiful photographs of *B.dermatitidis.*For more images please visit http://thunderhouse4-yuri.blogspot.com/2012/12/blastomyces-dermatitidis.html
References and further readings
- Saccente M, Woods GL. 2010. Clinical and laboratory update on blastomycosis. Clin Microbiol Rev 23:367–381. doi:10.1128/CMR.00056-09
- Blastomycosis. Center for Disease Control and Prevention.